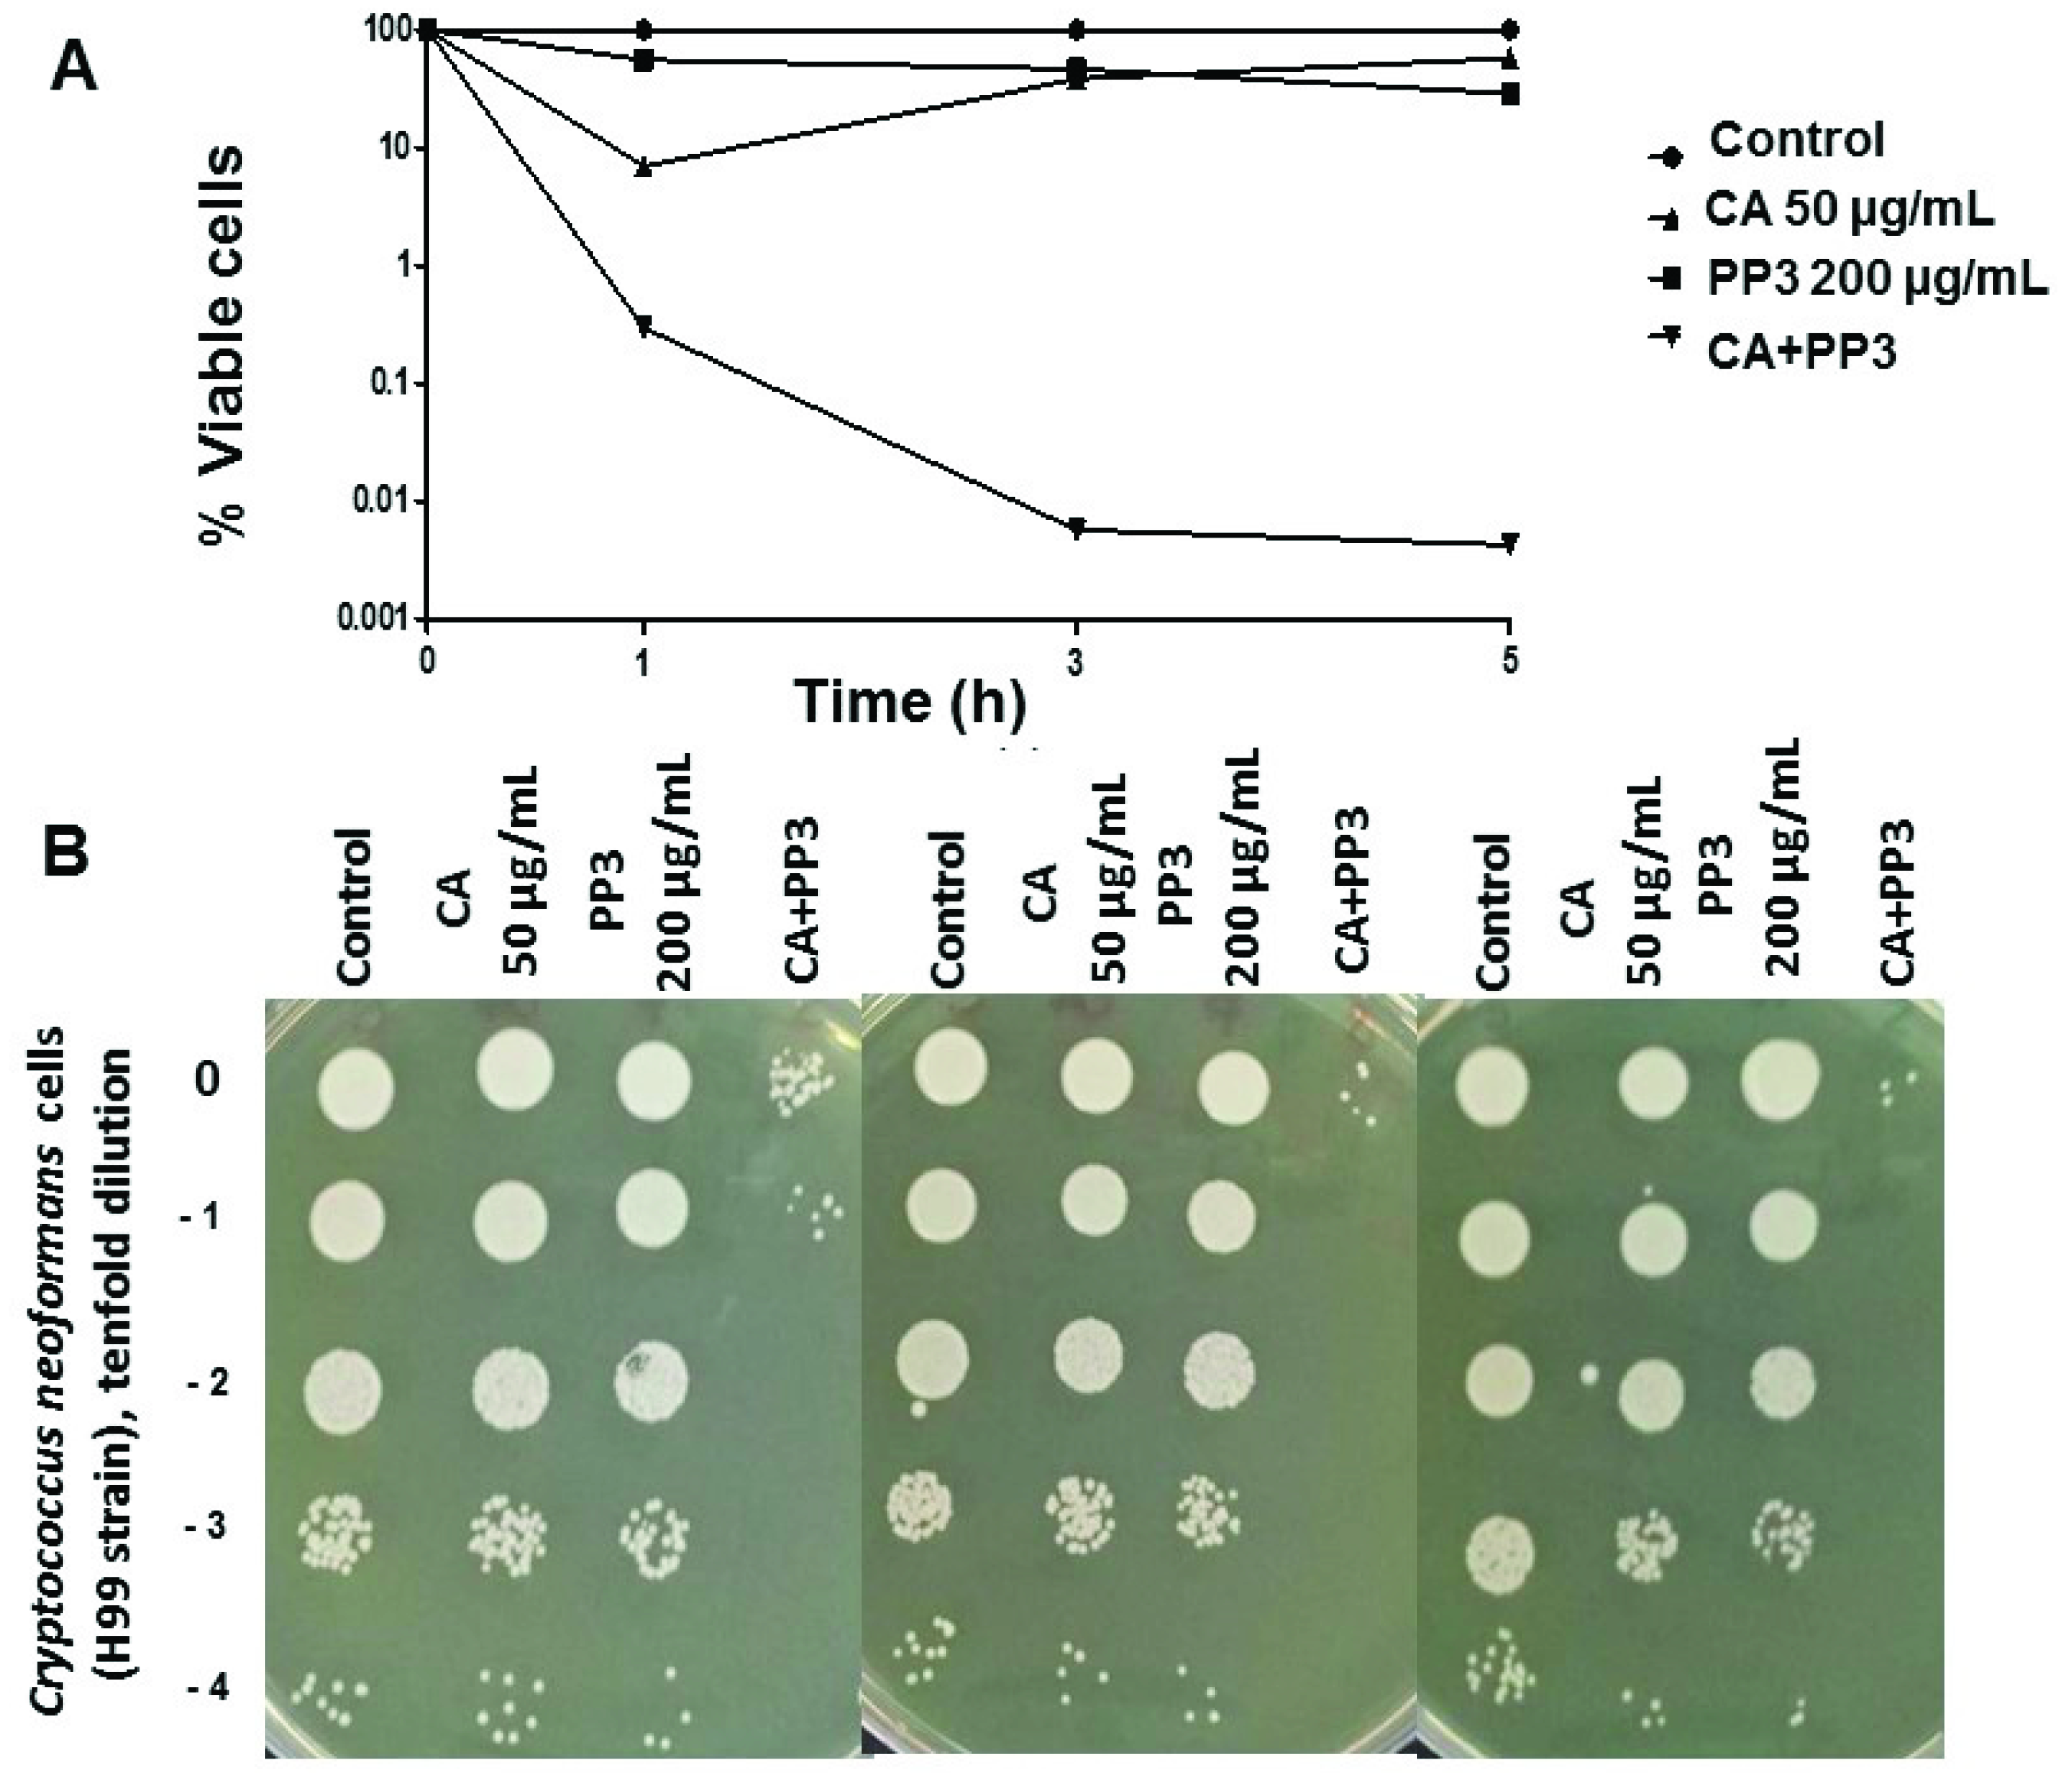
Antibiotics 10 01395 g003 Antibiotics 10 01395 g003

A Specific Mixture of Propolis and Carnosic Acid Triggers a Strong Fungicidal Action against Cryptococcus neoformans
Abstract
1. Introduction
2. Results
2.1. Study on the Antifungal Effect of Some Propolis and CA on C. neoformans
2.2. Analysis of the PP3 Extract and Semi-Purified CA by HPLC
2.3. Antifungal Activity of CA and PP Mixtures on C. neoformans
2.4. The Capacity to Form Biofilms by C. neoformans Is Impaired by the Addition of CA and PP3
3. Discussion
4. Materials and Methods
4.1. Yeast Strains and Culture Conditions
4.2. Natural Extracts
4.3. HPLC
4.4. Determination of Cell Viability
4.5. Morphological Analysis
4.6. Biofilm Formation
5. Conclusions
6. Patents
Supplementary Materials
Author Contributions
Funding
Institutional Review Board Statement
Informed Consent Statement
Acknowledgments
Conflicts of Interest
References
- Brown, G.D.; Denning, D.W.; Gow, N.A.R.; Levitz, S.M.; Netea, M.G.; White, T.C. Hidden killers: Human fungal infections. Sci. Transl. Med. 2012, 4, 165rv13. [Google Scholar] [CrossRef]
- Pfaller, M.A.; Castanheira, M. Nosocomial candidiasis: Antifungal stewardship and the importance of rapid diagnosis. Med. Mycol. 2016, 54, 1–22. [Google Scholar] [CrossRef] [PubMed]
- Campoy, S.; Adrio, J.L. Antifungals. Biochem. Pharmacol. 2017, 133, 86–96. [Google Scholar] [CrossRef]
- Gintjee, T.J.; Donnelley, M.A.; Thompson, G.R. Aspiring antifungals: Review of current antifungal pipeline developments. J. Fungi 2020, 6, 28. [Google Scholar] [CrossRef]
- Pfaller, M.A.; Diekema, D.J. Epidemiology of invasive mycoses in North America. Crit. Rev. Microbiol. 2010, 36, 1–53. [Google Scholar] [CrossRef]
- Zaragoza, O. Basic Principles of the virulence of Cryptococcus. Virulence 2019, 10, 490–501. [Google Scholar] [CrossRef]
- Mamoon, K.; Thammasit, P.; Iadnut, A.; Kitidee, K.; Anukool, U.; Tragoolpua, Y.; Tragoolpua, K. Unveiling the properties of Thai stingless bee propolis via diminishing cell wall-associated Cryptococcal melanin and enhancing the fungicidal activity of macrophages. Antibiotics 2020, 9, 420. [Google Scholar] [CrossRef] [PubMed]
- Thammasit, P.; Iadnut, A.; Mamoon, K.; Khacha-ananda, S.; Chupradit, K.; Tayapiwatana, C.; Kasinrerk, W.; Tragoolpua, Y.; Tragoolpua, K. A Potential of Propolis on major virulence factors of Cryptococcus neoformans. Microb. Pathog. 2018, 123, 296–303. [Google Scholar] [CrossRef]
- Nosanchuk, J.D.; Rosas, A.L.; Lee, S.C.; Casadevall, A. Melanisation of Cryptococcus neoformans in human brain tissue. Lancet 2000, 355, 2049–2050. [Google Scholar] [CrossRef]
- Rossi, S.A.; de Oliveira, H.C.; Agreda-Mellon, D.; Lucio, J.; Mendes-Giannini, M.J.S.; García-Cambero, J.P.; Zaragoza, O. Identification of off-patent Drugs that show synergism with Amphotericin B or that present antifungal action against Cryptococcus neoformans and Candida spp. Antimicrob. Agents Chemother. 2020, 64, e011921-19. [Google Scholar] [CrossRef] [PubMed]
- Bankova, V. Chemical Diversity of Propolis and the problem of standardization. J. Ethnopharmacol. 2005, 100, 114–117. [Google Scholar] [CrossRef]
- Huang, S.; Zhang, C.-P.; Wang, K.; Li, G.Q.; Hu, F.-L. Recent advances in the chemical composition of Propolis. Molecules 2014, 19, 19610–19632. [Google Scholar] [CrossRef] [PubMed]
- Silva-Carvalho, R.; Baltazar, F.; Almeida-Aguiar, C. Propolis: A complex natural product with a plethora of biological activities that can be explored for drug development. Evid.-Based Complement. Altern. Med. 2015, 2015, 206439. [Google Scholar] [CrossRef] [PubMed]
- Sforcin, J.M. Biological properties and therapeutic applications of Propolis. Phyther. Res. 2016, 30, 894–905. [Google Scholar] [CrossRef]
- Cigut, T.; Polak, T.Z.; Ga, L.; Raspor, P.; Jamnik, P. Antioxidative activity of Propolis extract in yeast cells. J. Agric. Food Chem. 2011, 59, 11449–11455. [Google Scholar] [CrossRef]
- De Castro, P.A.; Bom, V.L.P.; Brown, N.A.; de Almeida, R.S.C.; Ramalho, L.N.Z.; Savoldi, M.; Goldman, M.H.S.; Berretta, A.A.; Goldman, G.H. Identification of the cell targets important for Propolis-induced cell death in Candida albicans. Fungal Genet. Biol. 2013, 60, 74–86. [Google Scholar] [CrossRef]
- Bernardes, W.A.; Lucarini, R.; Tozatti, M.G.; Souza, M.G.M.; Andrade Silva, M.L.; da Silva Filho, A.A.; Martins, C.H.G.; Miller Crotti, A.E.; Pauletti, P.M.; Groppo, M. Antimicrobial activity of Rosmarinus officinalis against oral pathogens: Relevance of Carnosic acid and Carnosol. Chem. Biodivers. 2010, 7, 1835–1840. [Google Scholar] [CrossRef] [PubMed]
- Birtić, S.; Dussort, P.; Pierre, F.-X.; Bily, A.C.; Roller, M. Carnosic acid. Phytochemistry 2015, 115, 9–19. [Google Scholar] [CrossRef]
- Jordán, M.J.; Castillo, J.; Bañón, S.; Martínez-Conesa, C.; Sotomayor, J.A. Relevance of the Carnosic acid/Carnosol ratio for the level of Rosemary diterpene transfer and for improving lamb meat antioxidant status. Food Chem. 2014, 151, 212–218. [Google Scholar] [CrossRef]
- Argüelles, A.; Sánchez-Fresneda, R.; Guirao-Abad, J.P.; Belda, C.; Lozano, J.A.; Solano, F.; Argüelles, J.-C. Novel bi-factorial strategy against Candida albicans viability using Carnosic acid and Propolis: Synergistic antifungal action. Microorganisms 2020, 8, 749. [Google Scholar] [CrossRef] [PubMed]
- Benavente-Garcıa, O.; Castillo, J.; Lorente, J.; Ortuño, A.D.R.J.; Del Rio, J.A. Antioxidant activity of phenolics extracted from Olea Europaea L. leaves. Food Chem. 2000, 68, 457–462. [Google Scholar] [CrossRef]
- Sánchez-Fresneda, R.; Martínez-Esparza, M.; Maicas, S.; Argüelles, J.-C.; Valentín, E. In Candida parapsilosis the ATC1 gene encodes for an acid trehalase involved in trehalose hydrolysis, stress resistance and virulence. PLoS ONE 2014, 9, e99113. [Google Scholar]
- Guirao-Abad, J.P.; Sánchez-Fresneda, R.; Alburquerque, B.; Hernández, J.A.; Argüelles, J.-C. ROS formation is a differential contributory factor to the fungicidal action of Amphotericin B and Micafungin in Candida albicans. Int. J. Med. Microbiol. 2017, 307, 241–248. [Google Scholar] [CrossRef] [PubMed]
- Pierce, C.G.; Saville, S.P.; Lopez-Ribot, J.L. High-content phenotypic screenings to identify inhibitors of Candida albicans biofilm formation and filamentation. Pathog. Dis. 2014, 70, 423–431. [Google Scholar] [CrossRef]
- Guirao-Abad, J.P.; Pujante, V.; Sánchez-Fresneda, R.; Yagüe, G.; Argüelles, J.C. Sensitivity of the Candida albicans trehalose-deficient mutants tps1Δ and tps2Δ to Amphotericin B and Micafungin. J. Med. Microbiol. 2019, 68, 1479–1488. [Google Scholar] [CrossRef]
- Gucwa, K.; Kusznierewicz, B.; Milewski, S.; van Dijck, P.; Szweda, P. Antifungal activity and synergism with azoles of Polish Propolis. Pathogens 2018, 7, 56. [Google Scholar] [CrossRef]
- EUCAST. European Committee on Antimicrobial Susceptibility Testing Antifungal Agents Breakpoint Tables for Interpretation of MICs. Clin. Microbiol. Infect. 2018, 12, 501–503. [Google Scholar]
- Agüero, M.B.; Svetaz, L.; Sánchez, M.; Luna, L.; Lima, B.; López, M.L.; Zacchino, S.; Palermo, J.; Wunderlin, D.; Feresin, G.E.; et al. Argentinean andean Propolis associated with the medicinal plant Larrea Nitida Cav. (Zygophyllaceae). HPLC–MS and GC–MS characterization and antifungal activity. Food Chem. Toxicol. 2011, 49, 1970–1978. [Google Scholar] [CrossRef]
- Chee, H.Y. In vitro evaluation of the antifungal activity of Propolis extract on Cryptococcus neoformans and Candida albicans. Mycobiology 2002, 30, 93. [Google Scholar] [CrossRef]
- Davey, M.E.; O’toole, G.A. Microbial biofilms: From Ecology to Molecular Genetics. Microbiol. Mol. Biol. Rev. 2000, 64, 847–867. [Google Scholar] [CrossRef]
- Suleman, T.; van Vuuren, S.; Sandasi, M.; Viljoen, A.M. Antimicrobial activity and chemometric modelling of South African Propolis. J. Appl. Microbiol. 2015, 119, 981–990. [Google Scholar] [CrossRef]
- Fernandes, F.F.; Dias, A.L.T.; Ramos, C.L.; Ikegaki, M.; De Siqueira, A.M.; Franco, M.C. The “in vitro” antifungal activity evaluation of Propolis G12 ethanol extract on Cryptococcus neoformans. Rev. Inst. Med. Trop. São Paulo 2007, 49, 93–95. [Google Scholar] [CrossRef] [PubMed]
- Fernandes, F.H.; Guterres, Z.D.R.; Violante, I.M.P.; Lopes, T.F.S.; Garcez, W.S.; Garcez, F.R. Evaluation of mutagenic and antimicrobial properties of brown Propolis essential oil from the Brazilian Cerrado Biome. Toxicol. Rep. 2015, 2, 1482–1488. [Google Scholar] [CrossRef]
- Gardana, C.; Scaglianti, M.; Pietta, P.; Simonetti, P. Analysis of the polyphenolic fraction of Propolis from different sources by Liquid Chromatography–Tandem Mass Spectrometry. J. Pharm. Biomed. Anal. 2007, 45, 390–399. [Google Scholar] [CrossRef]
- Pellati, F.; Orlandini, G.; Pinetti, D.; Benvenuti, S. HPLC-DAD and HPLC-ESI-MS/MS methods for metabolite profiling of Propolis extracts. J. Pharm. Biomed. Anal. 2011, 55, 934–948. [Google Scholar] [CrossRef]
- Valencia, D.; Alday, E.; Robles-Zepeda, R.; Garibay-Escobar, A.; Galvez-Ruiz, J.C.; Salas-Reyes, M.; Jiménez-Estrada, M.; Velazquez-Contreras, E.; Hernandez, J.; Velazquez, C. Seasonal effect on chemical composition and biological activities of Sonoran Propolis. Food Chem. 2012, 131, 645–651. [Google Scholar] [CrossRef]
- Martorano-Fernandes, L.; Cavalcanti, Y.; de Almeida, L. Inhibitory effect of Brazilian Red Propolis on Candida biofilms developed on titanium surfaces. BMC Complement. Med. Ther. 2020, 20, 104. [Google Scholar] [CrossRef] [PubMed]
- Galletti, J.; Tobaldini-Valerio, F.K.; Silva, S.; Kioshima, É.S.; Trierveiler-Pereira, L.; Bruschi, M.; Negri, M.; Estivalet Svidzinski, T.I. Antibiofilm activity of Propolis extract on Fusarium species from Onychomycosis. Future Microbiol. 2017, 12, 1311–1321. [Google Scholar] [CrossRef] [PubMed]

Publisher’s Note: MDPI stays neutral with regard to jurisdictional claims in published maps and institutional affiliations. |
© 2021 by the authors. Licensee MDPI, Basel, Switzerland. This article is an open access article distributed under the terms and conditions of the Creative Commons Attribution (CC BY) license (https://creativecommons.org/licenses/by/4.0/).
Share and Cite
Argüelles, A.; Sánchez-Fresneda, R.; Martínez-Mármol, E.; Lozano, J.A.; Solano, F.; Argüelles, J.C. A Specific Mixture of Propolis and Carnosic Acid Triggers a Strong Fungicidal Action against Cryptococcus neoformans. Antibiotics 2021, 10, 1395. https://doi.org/10.3390/antibiotics10111395
Argüelles A, Sánchez-Fresneda R, Martínez-Mármol E, Lozano JA, Solano F, Argüelles JC. A Specific Mixture of Propolis and Carnosic Acid Triggers a Strong Fungicidal Action against Cryptococcus neoformans. Antibiotics. 2021; 10(11):1395. https://doi.org/10.3390/antibiotics10111395
Chicago/Turabian StyleArgüelles, Alejandra, Ruth Sánchez-Fresneda, Elisa Martínez-Mármol, José Antonio Lozano, Francisco Solano, and Juan Carlos Argüelles. 2021. "A Specific Mixture of Propolis and Carnosic Acid Triggers a Strong Fungicidal Action against Cryptococcus neoformans" Antibiotics 10, no. 11: 1395. https://doi.org/10.3390/antibiotics10111395
APA StyleArgüelles, A., Sánchez-Fresneda, R., Martínez-Mármol, E., Lozano, J. A., Solano, F., & Argüelles, J. C. (2021). A Specific Mixture of Propolis and Carnosic Acid Triggers a Strong Fungicidal Action against Cryptococcus neoformans. Antibiotics, 10(11), 1395. https://doi.org/10.3390/antibiotics10111395

